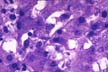

Li-7-2: PARASITIC INFESTATIONS
Contents: Amebiasis; Giardiasis; Cryptosporidiosis; Malaria; Visceral leishmaniosis; Toxoplasmosis; Schistosomiasis; Clonorchiasis; Fascioliasis; Echinicoccosis; Toxocariasis; Capillariasis; Pentostomiasis).
Amebiasis
Among various amebas, the Entamoeba histolytica is the one that invades tissues in man. As long as it remains in the lumen of the colon (luminal phase), it causes no problems. When it invades the bowel wall (invasive phase) it causes a diarrhoic syndrome and may spread to the liver where it forms amebic abscesses which are usually solitary. The patient experiences pain and tenderness in that region and general symptoms with fever. The diagnosis of abscess is made with imaging techniques. The diagnosis of amebiasis is made by serological tests for amebic antibodies. The treatment is by drugs and rarely surgical. The first association of ameba with liver abscess was described by Loesch in St. Petersburg, Russia, in 1875.The figure shows clusters of ameba trophozoites in the tissue, large, up to 60 microns in diameter. This is the active mobile form. They have one small eccentric nucleus and cytoplasmic vacuoles sometimes containing red cells. The cystic form with round shape and multiple nuclei does not occur in the tissues.
|
|
Fig.147-Entamoeba histolytica
Clusters of trophozoites in the tissue, large, up to 60 microns in diameter. This is the active mobile form. They have one small eccentric nucleus and cytoplasmic vacuoles often containing red cell. The cystic form with spherical shape and multiple nuclei does not occur in the tissues.
|
Giardiasis
This organism causes a diarrhoic syndrome. It rarely affects the liver where it can cause cholecystitis, cholangitis and granulomatous hepatitis. The diagnosis is made with light microscopy in the stools. This flagellate protozoan represents a historical curiosity. It was first seen by the inventor of the microscope, Leeuwenhoek, in 1881, in his own stools. Its pathological significance, however, was recognized tow hundred years later by Lambl of Prague in 1859. The organism in its tropho stage is flat, rounded at one end and pointed at the other end. It has tow paired nuclei and 4 pairs of flagella. The encysted form is smaller without flagella and four nuclei.
Cryptosporidiosis
Cryptosporidium is a parasite of domestic and wild animals. In normal humans it causes no damage but in immunocompromised individuals it can cause a protracted diarrhoic syndrome and cholecystitis and cholangitis in the liver. The diagnosis is made by light microscopy. This organism is acid-fast positive.
Malaria
There are four species of Plasmodium that cause disease in humans: P. falciparum, P.malariae, P. vivax, P. ovale. They have a sexual life cycle in the mosquito (sporogony) and an asexuals cycle in humans (schizogeny)They are transmitted by the female of the Anpheles mosquito. With their bites they inject sporozoites of these plasmodia into the blood stream. The organisms concentrate and proliferate in the liver where they form paranuclear masses( schizontes) visible even with a light microscope. Individual organisms (merozoites) are released from these masses and go to infect and destroy red cells. Schizontes of P.vivax and ovale may stay in hepatocyte for long time (hypnozoites) and cause relapses at distance of months and years; schizontes of P.falciparum and malariae do not have a long hepatic phase and develop into schizontes and merozoites in the red cells, capable to reinfect red cells but not hepatocytes. Gametocytes which develop from merozoites are sucked by mosquitoes to infect other individuals. There are, in summary two phases: extraerythrocytic and erythrocytic. Infected red cells will stick to endothelial cells of capillaries causing sequestration of red cells and disfunction of the microcirculation (anoxia) in various organs and fever. P.vivax and ovale cause benign tertian malaria; P. falciparum causes malignant tertian malaria; P. malariae causes quartan malaria. The malarial attacks consist of chills and fever recurring at 48 hour intervals for tertian and at 72 hour intervals for quartan type. Each attack lasts for-12 hours and coincide with the rupture of erythrocytes and release of a new pousse' of organisms. Hepatic involvement is rare and consists of Kupffer cell hyperplasia, deposition of malarial pigment, coarse, dark-brown(hemozoin), derived from hemoglobin altered by the plasmodium, in Kupffer cells and portal macrophages. It is negative for stainable iron. The hepatocytes show some non-specific unrest. Severe jaundice and cetrilobular necrosis similar to viral hepatitis may occur with falciparum infection. In tropical splenomegaly syndrome consisting of splenomegaly, thrombocytopenia and lymphocytosis, the liver may show marked sinusoidal lymphocytosis similar to infectious mononucleosis.
Visceral leishmaniasis (kala-azar)
It is due to Leishmania donovani transmitted by sandflies, Phlebotomus in Eurasia and Africa and by Lutzomya in Brasil. It is endemic in the Mediterranean basin India, Northern China, east Africa and Brazil. Dogs and rats appear to function as reservoirs. The clinical picture consists of fevers , malaise and progressive hepatosplenomegaly lymphadenopathy, pancytopenia, cachexia. The spleen becomes lather hard. The liver contains numerous L-D bodies in Kupffer cells stainable with H&E and Giemsa. There is effective treatment with pentavalent antimonials, aromatic diamadines and amphotericin B.
|
| Fig.148-Leishmania donovani
Clusters of rounded bodies, 2-3 microns in length inside macrophages and endothelial cells in hepatic sinusoids. This is the leishmania form. In culture and in insects they exist as flagellated form with a single long flagellum.
|
Toxoplasmosis
It is due to Toxoplasma gondii, so-called because it was found in a rat by the name gondi in North Africa. It is acquired from raw meat and cat feces. It affects immunosuppressed individuals. It is a major intercurrent infection in cardiac and liver transplants. Fetuses are infected from the placenta and develop severe brain damage. Fluorescent antibody test for IgG and IgM are the best for diagnosis. It is readily seen in H&E sections. It is treatable.
Schistosomiasis
Schistosoma are trematodes (flat worms). The species that cause infestation in men are: S. mansoni, S. japonicum , S. intercalatum, S. mekongi which parasitize the intestinal venules and capable of spreading to the liver and Schistosoma hematobium which resides in the vesical venules and damage the urinary bladder and ureters. The first of these parasites (hematobium) was discovered in Egypt in 1852 by a German pathologist, Bilharz. These organisms infect millions (200) of people in Asia , Africa and South America mainly Egypt, Nigeria, China (japonicum), Subsaharan Countries and Caribbean islands, Brazil and Venezuela in the Americas(mansoni).S.hematobium Is scattered trough Africa bu it is concentrated in the Nile valley. Man contracts the infection from fresh water snail which release the cercarial form of the worm in the water. The cercariae are motile and penetrate the human skin or mucosae, enter the circulation, pass through the lungs ad lodge in the hepatic branches of the portal vein where they become adult worms, male and female. They copulate, leave the liver and migrate to the fine intestinal radicals of the inferior mesenteric vein especially around the colon and rectum. The S. mansoni and japonicum reach the little venules of the colonic and rectal submucosa where the female releases her ova. The eggs erode the mucosa and fall into the colonic lumen, are defecated and go to infect other snails where new cercariae are formed thus restarting the cycle. Many ova from the colonic mucosa instead of being extruded into the intestinal lumen are extruded into the portal circulation, they reach the liver where they produce the typical periportal fibrosis. Sometimes in the case of S.mansoni, adult worms are seen in the hepatic branches of the portal vein. The mature worms are flat and measure 10 to 16 mm in length depending on the species. The female is thinner and longer than the male. The ova vary in size and shape according to the species. The ova of S.mansoni have a characteristic lateral spine.
The morphological changes in the liver consist of granulomas with giant cell, epithelioid cells containing ova of the parasite. The granulomas are mostly located in the portal fields where they produce a stellate fibrosis of "clay pipestem"type which is appreciated in the cut surface of the liver. This fibrosis produces portal hypertension due to occlusion of portal vein radicals but does not cause cirrhosis. If there is cirrhosis it is due to hepatitis B associated with schistosomiasis in the same geographic areas.
|
| Fig.149-Schistosoma mansoni
Eggs in the venules of the intestinal mucosa which are shed into the intestinal lumen and the environment where they release their miracidia which go to parasitize the snails. The eggs are about 150 microns in maximum diameter. The lateral spine cannot be seen in this section.
|
|
| Fig.150-Schistosoma mansoni
Section of infested liver with periportal fibrosis which, on cut section is so dense as to resemble a pipe stem.
|
Clonorchiasis
Clonorchis (opistorchis) sinensis is a flat fluke, 10-25 mm in length and 3-5 mm in width, reddish, transparent that resides in the major intrahepatic bile ducts. It is found mainly in the Far East. It is acquired by eating row or poorly cooked fish which carry the eggs of this parasite in their scales. The infection causes dilatation of intrahepatic bile ducts resembling cysts and may cause purulent cholangitis with multiple liver abscesses due to E.coli. The presence of the fluke induces glandular hyperplasia of the bile ducts with increased mucus secretion. The glandular hyperplasia may be prominent and adenomatous. Cholangicarcinoma is associated with this infestation. Other tow similar trematodes are found in Poland and Siberia (Opistorchis felineus)
and in Thailand (Opistorchis viverrini). They cause a disease similar to O.snensis and are associated with cholangiocarcinoma.
Fascioliasis
Fasciola hepatica (sheep liver fluke) is a fluke measuring about 30mm in length and 13mm in width. The distribution is world-wide especially in sheep-raising countries. It is acquired by ingestion the cercariae which develop in the snails and are released in the grass near water streams. After being ingested with grass by sheep or by humans with watercress salad, they penetrate the duodenal wall and enter the peritoneum. They penetrate into the liver through the glissonian capsule and lodge in the bile ducts producing obstruction but not cholangicarcinoma. The liver may show indurated nodules at the surface which indicate the passage of the parasite. Hepatitic colic , jaundice and fever may be part of the symptoms in humans. It may cause bleeding and anemia. In the middle East this parasite may cause a syndrome named halzoun which is a suffocating illness due to lodging of the parasite in the pharynx due to ingestion of contaminated sheep livers. It is treated with emetine hydrochloride.
Echinococcosis (Hydatid Cyst)
It is due to the larval form of short tapeworms of the genus Echinococcus. The species of Echinococcus granulosus is the most common. The cystic disease was known to Hippocrates but it took about 2000 years to identify the responsible agent, the worm, which was discovered only in 1808 by Rudolphi in Germany. The worm is 3 to 6 mm long and lives attached to the villi of the small intestine of canines (dogs and foxes).It has a head and three proglottides the terminal being the one gravida with eggs. It lives between 5 and 20 months in the dog and when it is evacuated, the gravid proglottis bursts releasing the eggs. The eggs are picked up and ingested by the intermediate hosts that can be sheep, hogs ,ox and man . In the can expand to a large size. Their wall is made of a thick cuticle with an inner layer of proliferation of the parasite, protoscolices, small cysts containing scolices which, like granules fall in the lumen full of liquid and may form daughter cysts. The scolices contain suckers and hooklets which can be seen under the microscope. Rupture of the cyst will disseminate the infection and may result in a serious anaphylactic shock. Dogs that eat the cysts will develop the terminal form of the worm in their intestine. Diagnosis is made by serology. Treatment consists of surgical removal of the intact cyst. A more aggressive variant of echinococcosis is produced by Echinococcus multilocularis. The terminal host is the fox and the intermediate hosts are rodents. The cysts are multiple and smaller. Humans can contract it. It is found around the Alps, Alaska, Canada, China. It is More aggressive and more difficult to control than Echinococcus granulosus.
|
| Fig.151-Echinococcus granulosus
Liver with a hydatid cyst containing fluid and daughter cysts. Notice the thick connective tissue capsule which cannot be broken in attempting to remove the cyst.
|
|
| Fig.152-Histological section of the above
Section of daughter cysts showing the germinal layer with attached scolices.
|
Ascariasis
It is due Ascaris lumbricoides, the giant round intestinal worm. It has world wide distribution. It is acquired by ingesting the eggs which are produced by the female in millions. In the duodenum, the larvae of these eggs penetrate the wall, enter the mesenteric lymphatics or the hepatic venules and reach the heart and the lungs. Here they invade the air spaces and through bronchioli and bronchi they reach the epiglottis and are swallowed in the stomach able to resist the gastric juices. They reach the intestine and mature into males and females an restart the cycle. From the lungs they may reach the left heart and become distributed to every organ where they cause acute tissue reactions. The larvae in the lungs may cause ascaris pneumonitis: Mottling of the lungs, dyspnea, high fever. In the liver , the larvae may produce granulomas. The adult worms in the intestine cause colicky pains and fever in children, also, appendicitis, blockage of the ampulla of Vater and common bile duct, hemorrhagic pancreatitis. Metabolites of the worm cause sensitization phenomena: bronchial asthma, urticaria, conjunctivitis , palpebral edema. There is efficient treatment with hexylresorcinol.
Toxocariasis.
Toxocara canis and T.catis are intestinal ascarids of dogs and cats. In humans, their ingested larvae migrate to the liver where they form granulomas in the portal tracts. The disease is more frequent in children being more in contact with dogs. The liver is the most affected organ. Here the granulomas can be seen as small-size whitish spots under the capsule. Invasion of other organs may also occur. The granulomas are mostly composed of eosinophil with some histiocytes at their periphery. There may be rare giant cells. The larva in these granulomas is not always seen, but their morphology with the history of exposure to dogs is sufficient for the diagnosis. There are no reliable serological tests. The prognosis is favorable in the majority of cases. The infection of the eye requires enucleation. Administration of antielmintics to dogs and cats is the best method of prevention. There is no specific therapy.
Capillariasis
It is due infestation with Capillaria hepatica, a common worm parasite of rats, and les commonly of squirrels, maskrat, hare beaver, chimpanzee and other monkeys. Few cases have been reported in man. The worm liver in the liver where it deposits its eggs. The eggs cause necrosis and fibrosis in the li and are not released in the feces.The infestation is contracted by injesting the infected liver. The worm and and eggs resemble Trichuris. The eggs have a birefringent. There is no treatment.
Pentostomiasis
Is due to "tongue worms", because the adult forms are elongated like tongues. Two genera affect man, Armillifer armillatus and Linguatula serrata. They live mainly in the respiratory passages of snakes but also in birds and nares of mammals where they produce eggs which are released in the environment. Contamination occurs by ingesting the eggs with larvae which spread through various organs forming encysted ninphae which at the surface of the liver form small encapsulated whitish nodules very similar to fasciola infestation.
CONTENTS